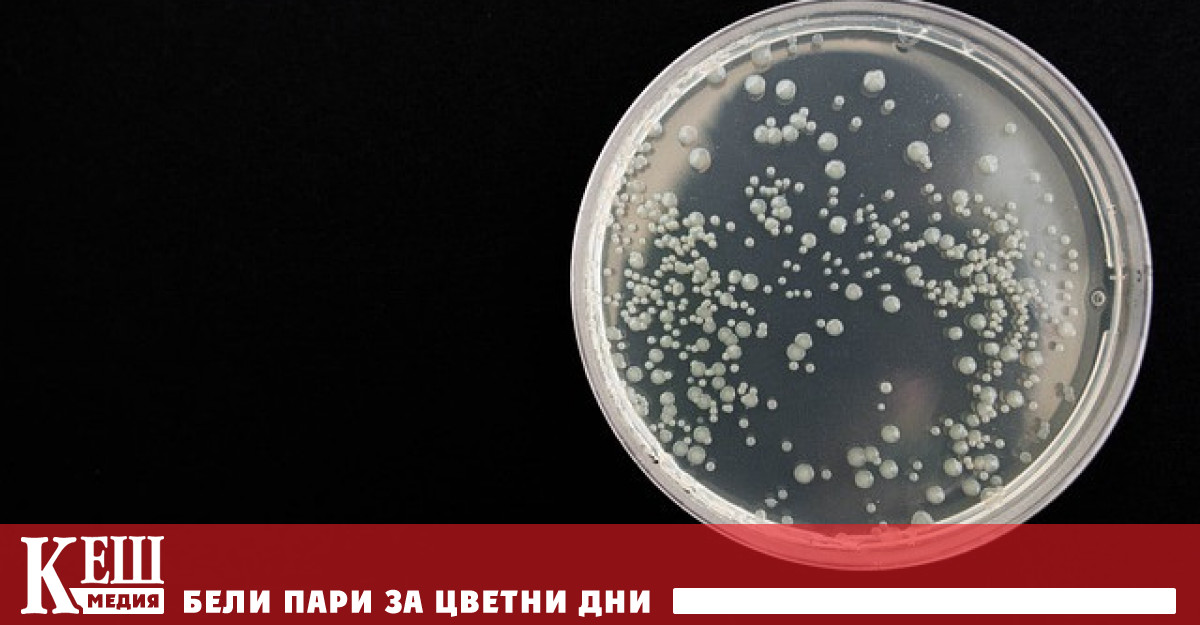
Това съобщава Associated Press Повече от 10 милиона души по света

... Преди това се очакваше той да бъде 3,3% от БВП. Агенцията очаква Италия да започне постепенно да намалява публичния си дълг, считано от 2027 г.
Повиши Първи - Новини
Международната рейтингова агенция Fitch повиши кредитния рейтинг на Италия от
...... 3,8%. Според финансовия министър Джанкарло Джорджети дефицитът може да падне под тавана на ЕС от 3% още тази година – една година по-рано от предвиденото.
Международната рейтингова агенция Fitch повиши кредитния рейтинг на Италия от
...... 3,8%. Според финансовия министър Джанкарло Джорджети дефицитът може да падне под тавана на ЕС от 3% още тази година – една година по-рано от предвиденото.
Международната рейтингова агенция Fitch повиши кредитния рейтинг на Италия –
...... обстановка е благоприятна за постигането на финансовите цели на Италия, а новият процес на многогодишно планиране служи като важна опора за поддържане на фискална предпазливост.
Цената на среброто достигна нов 14 годишен връх около 40 70 долара
...... около 3470 долара. Очакванията са до края на годината златото да достигне рекордните 3600 долара за тройунция, според анализатори, анкетирани от The Wall Street Journal.
СподелиНай голямата верига за търговия на дребно в САЩ Уолмарт Walmart
...... акциите на „Уолмарт“ се търгуват с над 4 процента по-ниско спрямо затварянето от предходния ден.Източник БТАЗа още интересни новини, интервюта, анализи и коментари харесайте !
if DIR hasOwnProperty sectionId DIR sectionId includes 136 Hide ads
...... такива, които насърчаваха точно обратното. Дали бойкотът е бил успешен, ще стане ясно най-рано на 14 февруари, когато магазините ще имат данни за оборота си от четвъртък.
Международната агенция за кредитен рейтинг Moody s Ratings повиши кредитния рейтинг
...... - Standard & Poor`s и Fitch - определят кредитен рейтинг на Аржентина на ниво "CCC". Милей започна приватизацията в Аржентина Продаде металургичен гигант на американци
Международната рейтингова агенция Moody s повиши кредитния рейтинг на Аржентина до
...... биха могли да доведат до „значителни загуби“ за притежателите на облигации. Другите агевции Standard & Poor`s и Fitch оценяват кредитния рейтинг на Аржентина на CCC.
След 2021 г това е първия положителен тренд с който
...... ефектът от което е нулев. „Нашата формула е различна – румънският модел, който наистина да доведе до ефективни и дълги присъди на политици“, подчерта Иванов.
Международната рейтингова агенция Moody s Ratings обяви че е повишила рейтингите
...... заради недостроена магистрала, финансирана от Китай. Страната обяви нов подобен проект Да имаш зад гърба си финансиране от Китай има предимства, но и подводни камъни
В опит да стимулира икономиката на страната през 2016 г
...... BOJ от 2%.Решението най-накрая да се повишат лихвите зависи от готовността на големите корпорации в страната да увеличат заплатите на... Прочетете целия материал в cash.bg
Централната банка на Япония повиши основния си лихвен процент за
...... очакваше, сложи край на осемте години на отрицателни лихвени проценти и постави началото на първото затягане на националната политика от 2007 г. насам, отбелязва Reuters.
Централната банка на Япония повиши референтния си лихвен процент за
...... по отношение на нейния номинален брутен вътрешен продукт или БВП. Икономиката на САЩ е най-голямата, следвана от Китай, която изпревари Япония преди повече от десетилетие.
Коефициентът на плодовитост на тийнейджърите в Тексас се повиши за
...... абортите. Това доведе до лоши здравни резултати за децата и майките и ще продължи през следващите години, каза тя. За още от NBC Latino, .Сузан Гамбоа
Износът на Китай се повиши леко през ноември прекъсвайки шестмесечния
...... спрямо година по-рано, докато износът за САЩ, третият по големина търговски партньор, намаля с 8,5 процента.Допълнителни доклади от Анди Лин и Уилям Лангли в Хонконг
Митническите данни показват че износът на Китай се е увеличил
...... опитва да увеличи износа за Китай. Ограниченията върху износа на чувствителни технологии са дългогодишен спор между Пекин и САЩ и други западни нации. Водещи истории
Китай се бори с бавна външна търговия тази година на
...... и централните банки в Европа и Азия започнаха да повишават лихвените проценти миналата година, за да охладят инфлацията, която беше на върхове от няколко десетилетия.
Китайският производител на потребителска електроника Xiaomi реализира нетна печалба през
...... от 1%. Xiaomi продадоха телефони за над $3 млрд. долара за броени дни в Китай Денят на необвързаните в страната е съпроводен с големи отстъпки
Лидерът в застраховането на търговски кредити на глобално ниво и
...... евро. Към момента в България застрахованите експозиции достигнаха обща стойност над 2 млрд. eвро, като компанията се утвърждава убедително като лидер на националния пазар.
Международната рейтингова агенция S P Global Ratings Стандард енд Пуърс е
...... началото на годината измерителят е нараснал с 244 пункта и с 26.23%, което също е знак за инвеститорско доверие към икономиката на южната ни съседка.
Основният индекс на Българската фондова борса SOFIX падна под 750
...... Холдинг" с 10. Няколко компании на БФБ с повишаващ се дивидент през последните три години Инвеститорите в много по-голяма степен се интересуват от капиталовата печалба
Борсовата цена на руското лятно дизелово гориво за първи път
...... седмици. Самолетното гориво поевтиня с 0,64 на сто до 71 263 хиляди рубли за тон (726,43 щ. долара), след като вчера също достигна исторически ценови максимум.
Цената на биткойн се повиши рязко и премина 30 000
...... над $64 000 в края на 2021 година. Подготвя се глобална регулация на крипто пазара Инициативата е на глобалния орган на комисиите по ценни книжа
Българската народна банка обяви основен лихвен процент в размер на
...... от 2016 г. За януари лихвеният процент бе обявен в размер на 1,42 на сто, а за февруари – в размер на 1,82 на сто.
Българската народна банка определи основният лихвен процент от днес да
...... към нарастване.Размерът на основния лихвен процент се изчислява като средната аритметична величина от стойностите на индекса ЛЕОНИА Плюс за работните дни на предходния календарен месец.
Словакия за първи път в историята на държавата повиши нивото
...... оръжие. Както подчертаха във ведомството, снимките на останките, публикувани от полските медии от мястото на инцидента, не са на руски оръжия. Източник: агенция TASR / ФОКУС
Това съобщава Associated Press Повече от 10 милиона души по света
...... на случаите на туберкулоза, заявявайки, че пандемията „продължава да има опустошително въздействие върху достъпа до диагностика и лечение на туберкулоза“.... Прочетете целия материал в cash.bg
Българската народна банка повиши основния лихвен процент за първи път
...... затягане на паричната политика в опит да овладеят ускорената инфлация. В България размерът на ОЛП се прилага предимно при изчисляването на законната лихва за забава.
Управителният съвет на Европейската централна банка ЕЦБ за първи път
...... за инфлация от 2%. Управителният съвет възнамерява да реинвестира основните плащания по ценни книжа по програмата PEPP с падеж поне до края на 2024 г.
Управителният съвет на Европейската централна банка ЕЦБ за първи път
...... за инфлация от 2%. Управителният съвет възнамерява да реинвестира основните плащания по ценни книжа по програмата PEPP с падеж поне до края на 2024 г.
Управителният съвет на Европейската централна банка ЕЦБ за първи път
...... цел за инфлация от 2%.Управителният съвет възнамерява да реинвестира основните плащания по ценни книжа по програмата PEPP с падеж поне до края на 2024 г.
Управителният съвет взе решение да повиши трите основни лихвени процента
...... цел за инфлация от 2%. Управителният съвет възнамерява да реинвестира основните плащания по ценни книжа по програмата PEPP с падеж поне до края на 2024 г.
Управителният съвет на Европейската централна банка ЕЦБ за първи път
...... за инфлация от 2%.Управителният съвет възнамерява да реинвестира основните плащания по ценни книжа по програмата PEPP с падеж поне до края на 2024 г. /БГНЕС
Управителният съвет на Европейската централна банка ЕЦБ за първи път
...... цел за инфлация от 2%.Управителният съвет възнамерява да реинвестира основните плащания по ценни книжа по програмата PEPP с падеж поне до края на 2024 г.
Управителният съвет реши да повиши трите ключови лихвени процента на
...... депозитната линия ще бъдат увеличени до 1,25%, 1,5% и съответно 0,75% от 14 септември 2022 г.“, се казва в съобщението.... Прочетете целия материал в cash.bg
McDonald s повиши цената на своя чийзбургер за първи път от
...... Канада - 5,25 долара В България сандвич Big Mac се продава за 8,60 лева или $4,46. McDonald`s има повече от 36 000 ресторанта в повече от 100 страни.
Европейската централна банка ЕЦБ повиши водещата си лихва с 0 5
...... ще й позволи да купува облигации, когато забележи признаци за финансова фрагментация - необосновани отклонения в цената на кредитирането сред 19-те държави от валутния съюз.
Управителният съвет на Европейската централна банка реши да повиши трите
...... процент по заеми на ЕЦБ е 0,75%, пише БГНЕС. Отбелязва се, че на предстоящите заседания на ЕЦБ са възможни допълнителни увеличения на лихвените проценти.Снимка: БГНЕС
Европейската централна банка обяви очакваното първо повишение на лихвите си
...... на паричната политика в цялата еврозона. Мащабът на покупките по TPI зависи от сериозността на рисковете за предаването на политиката. Покупките не са предварително ограничени.
Европейската централна банка ЕЦБ обмисля на днешното си заседание да
...... на природен газ за Европа, са съобщили за Ройтерс източниците, близки до дискусиите в ЕЦБ. Говорител на Европейската централна банка е отказал коментар по темата.
Европейската централната банка ЕЦБ ще повиши лихвените проценти от 1
...... нарасващите цени на основни суровини.В началото на миналия месец Федералният резерв също повиши лихвените нива и то с 0.50% - рекорден ръст от 22 години.
Полша неочаквано повиши лихвите за първи път от 2012 г
...... да достигне 2% спрямо 1,5% преди пандемията. „Това не е краят. Очакваме голяма фискална експанзия през 2022 г. и висока инфлация“, отбелязаха те в Twitter.
Редактор e mail Снимка ПиксабейЦената на декемврийския фючърсен договор за суровината Brent на
...... над 80 долара за първи път от 2018 г. Цената на черното злато WTI по време на търговията на 4 октомври също постави рекорд, пише Life.ru.Превод: "Петел"
Германският конгломерат Thyssenkrupp повиши годишната си прогноза за първи път
...... 78 млн. евро. „Почти не помня кога последно видяхме такова нещо“, коментира трейдър, пожелал анонимност, имайки предвид печалбата за тримесечието на оперативните звена на компанията.
De Beers повиши цените на диамантите за първи път от
...... стимулираме допълнително производство, ако не сме уверени, че цените ще нараснат“, коментира Марк Кутифани, главен изпълнителен директор на компанията майка на De Beers, Anglo American.
Турската централна банка повиши лихвените си проценти за първи път
...... още може да се окаже недостатъчно за стабилизиране на лирата по устойчив начин, без администрацията на Ердоган да постигне напредък в структурните реформи“, коментира той.
За първи път от седем години Шведската централна банка повиши
...... обясниха още от банката. Главният икономист на Шведкста централна банка Анна Бреман не смята, че ще има друго увеличение на лихвите преди септември следващата година.





&format=webp)